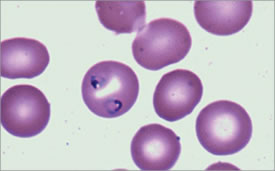

This year is the bicentennial of the birth of Charles Darwin and the sesquicentennial of the publication of On the Origin of Species. For thousands of years the principles of evolution have been played out in the minuet between the malaria parasite and the red blood cell. Survival of the human species has depended upon genetic resistance to malaria across the globe. Evolutionary anti-malarial strategies have included inhibition of intracellular growth, release of mature merozoites or entry into the red cell, promotion of phagocytosis and immune clearance of infected cells, and prevention of vascular or blood cell adherence of infected red cells. Selective pressure has led to high frequencies of otherwise rare RBC genes in certain populations in Africa, Southeast Asia, the Mediterranean, and elsewhere that lessen malarial morbidity and mortality.1 For example, hemoglobinopathies, including S, C, E, and thalassemia; metabolic abnormalities, such as glucose-6-phosphate dehydrogenase deficiency; cytoskeletal membrane defects like ovalocytosis or elliptocytosis; and red cell surface antigens, such as the Duffy blood group system, glycophorins, ABO molecules, and complement receptors, all have been linked to genetic resistance to malaria.2,3,4
Characteristic Ring Forms can be Seen Within the Erythrocytes. From Maslak, P. ASH Image Bank. 2008:8-00003.
Characteristic Ring Forms can be Seen Within the Erythrocytes. From Maslak, P. ASH Image Bank. 2008:8-00003.
The life cycle of the Plasmodium falciparum malarial parasite begins when the anopheles mosquito injects sporozoites into a human. These go to the liver where a mature schizont eventually ruptures merozoites into the blood stream where they invade uninfected erythrocytes to begin the erythrocytic phase of infection. Infected erythrocyte schizonts can also release merozoites (see Figure). Erythrocyte invasion depends on ligands on the merozoite and host receptors on the erythrocyte membrane. An example is the Duffy blood group system and its role in determining susceptibility to Plasmodium vivax infection. Duffy-negative erythrocytes resist invasion of Plasmodium vivax merozoites, and Duffy-negative individuals are hence resistant to infection if exposed to mosquitos infected with Plasmodium vivax.5
Plasmodium falciparum has a family of genes encoding erythrocyte-binding proteins related to the Duffy-binding proteins of vivax. Several of these have been shown to bind to glycophorins A and C on erythrocytes, but the erythrocyte receptor for one, EBL-1, was not known. Mayer et al., from Louis Miller’s group at Virginia Commonwealth, have now shown that EBL-1 binds glycophorin B.They first showed, by confocal microscopy, that EBL-1 was localized on a Plasmodium falciparum clone Dd/Nm and that it was only expressed in the late schizont phase of infection. EBL-1 could bind to erythrocytes, but this was blocked if the erythrocytes were pre-treated with neuraminidase or chymotrypsin, but not trypsin. The requirement for sialic acid for binding is a characteristic of glycophorin B and indeed glycophorin B-null erythrocytes did not bind EBL-1. When EBL-1 was expressed on CHO cells they acquired capacity to bind glycophorin B+ but not glycophorin B-null erythrocytes. Glycophorin B+ cells treated with neuraminidase and chymotrypsin did not bind EBL-1-expressing CHO cells.
In Brief
Thus, in this year of celebrating Darwin, it is exciting that another example of natural selection in the battle against Plasmodium falciparum malaria has been discovered. This study gives further molecular basis to the observations that Klebs and Tomassi-Crudeli made in 18886 in regard to malaria resistance of those of African descent. The glycophorin B gene has a high degree of polymorphism in malaria-endemic areas, leading often to loss of expression; glycophorin B deficiency is found in 59 percent of the Efe pygmies of the Ituri Forest in the Democratic Republic of Congo, and the authors speculate that it provides them resistance to infection. The elegant studies outlined above provide robust evidence for this conjecture. These lessons of natural selection provide insights for new therapies against this world-wide scourge. Two hundred years after Darwin’s birth, hematologists peer into the red blood cell to better understand the balance of nature.
References
Competing Interests
Dr. Vercellotti indicated no relevant conflicts of interest.